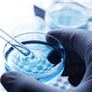

Co je třeba vědět o biologických na RA
Významného pokroku bylo dosaženo v léčbě revmatoidní artritidy (RA) vzhledem k nové třídě léků nazývaných biologickými. Biologics práce tím, že blokuje imunitní odpověď, která vede k bolestivé příznaky RA. Oni jsou také účinné v asi 2/3 pacientů, kteří je používají. Přečtěte si více o těchto zajímavých vylepšení ›
Bližší pohled na biologických
Jsou všechny biologickými stejné? Můžete mít více než jeden po druhém? Jaké jsou nejčastější vedlejší účinky? Dokonce i když jste se snažil biologických předtím, získat odpovědi na tyto nejčastější otázky ›
Prosperující s RA

Obývací dobře s RA znamená mít plán léčby, při dobré péči o sebe a vědět, jak bojovat proti vzplanutí a komplikací. Zkuste těchto 8 tipů pro zdravý život s RA ›




